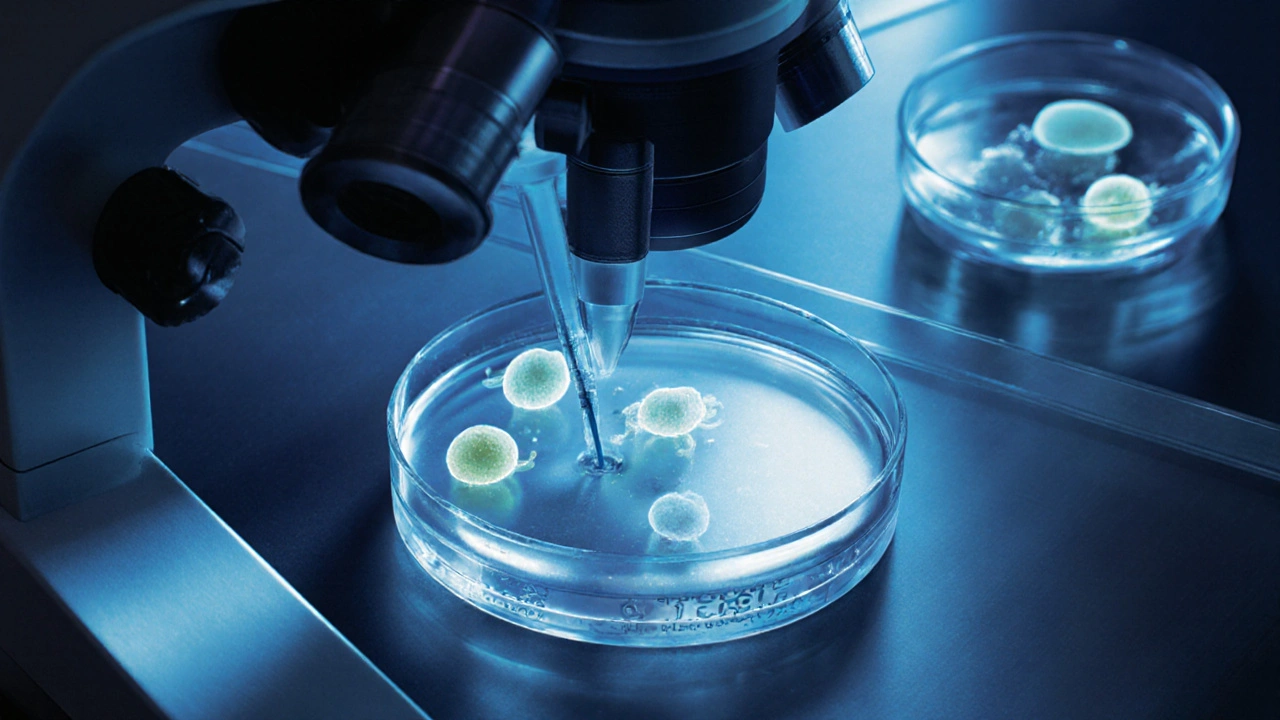
Laboratorní pohled na vývoj embryí a mikroinjekci spermie v petriové mísce.

Umělé oplodnění: Estimátor nákladů
Zjistěte, kolik vás bude stát umělé oplodnění v ČR
Zadejte typ postupu a svůj věk a zjistíte odhadnuté náklady s ohledem na veřejné zdravotní pojištění.
Pokud už dlouho zkoušíte mít dítě a přirozená cesta nevede, nejste sami. V České republice každá sedmá párka čelí problémům s plodností. Ať už je příčinou problém u ženy, muže nebo obou, dnes existuje více než jedna cesta, jak překonat neplodnost. Umělé oplodnění už není nic neobvyklého - je to běžná medicínská možnost, která každý rok pomůže tisícům párům. Ale co vlastně tyto metody znamenají v praxi? A co mezi nimi vybírat?
Co je umělé oplodnění a kdy se používá?
Umělé oplodnění je lékařský postup, při kterém se spermie uměle přivádí k vajíčku mimo tělo nebo přímo do ženského těla. Cílem je zvýšit šanci na oplodnění, pokud přirozená cesta selhává. Používá se, když:
- muž má nízký počet nebo špatnou pohyblivost spermií
- žena má blokované vaječníky nebo problémy s vývodovými trubkami
- je neznámá příčina neplodnosti
- se používají darované spermie nebo vajíčka
- žena má problémy s ovulací
Nejde o zázrak, ale o vědecky podloženou metodu, která má jasná kritéria a vysokou úspěšnost - pokud je správně aplikovaná. V České republice se ročně provede přes 10 000 cyklů umělého oplodnění, z nichž téměř třetina vede k těhotenství.
Nejjednodušší metoda: IUI - vnitřní inseminace
IUI, neboli vnitřní inseminace, je nejjednodušší a nejméně invazivní metoda. Spermie se nejprve připraví v laboratoři - odstraní se nekvalitní a pomalé, zůstanou jen ty nejaktivnější. Poté se přímo vloží do dělohy prostřednictvím tenkého katétru. Proces trvá pár minut a není bolestivý.
Tato metoda se hodí, pokud:
- muž má mírně sníženou kvalitu spermií
- žena má problémy s krčkem dělohy nebo nevyskytuje se přirozená hlenová tekutina
- se používají darované spermie
- je příčina neplodnosti neznámá
Úspěšnost IUI je kolem 10-15 % za jeden cyklus. Největší šance je v prvních třech pokusech. Pokud po třech pokusech není těhotenství, lékaři doporučují přejít na složitější metody.
Nejčastější metoda: IVF - in vitro fertilizace
IVF je nejznámější a nejčastěji používaná metoda. Znamená to, že vajíčko a spermie se spojí mimo tělo - v laboratoři. Žena nejprve podstoupí hormonální podporu, aby vytvořila více vajíček. Poté se vajíčka odběrnou procedurou (pod lehkou anestézií) vyberou. Spermie se přidají k vajíčkům a nechají se spolu působit 12-48 hodin. Pokud dojde k oplodnění, vznikají embrya.
Po 3-5 dnech se jedno nebo dvě nejlepší embrya přenesou do dělohy. Zbytek může být zamražen pro budoucí cykly.
Úspěšnost IVF se pohybuje kolem 30-40 % na jednu přenosovou proceduru u žen do 35 let. U žen nad 40 klesá na 10-15 %. V ČR je IVF částečně hrazena z veřejného zdravotního pojištění - maximálně tři cykly do věku 39 let.
Pro muže s těžkou neplodností: ICSI - mikroinjekce spermie
ICSI je modifikace IVF, která se používá, když spermie jsou příliš málo, pomalé nebo poškozené. Namísto toho, aby se spermie samy „pokusily“ oplodnit vajíčko, lékař jedno vajíčko zafixuje a pomocí tenkého jehlového nástroje do něj přímo vloží jednu spermii.
Tato metoda je ideální pro:
- muže s velmi nízkým počtem spermií (oligozoospermií)
- muže s nulovým počtem spermií v ejakulátu, ale s přítomností v varlatech (tzv. TESE)
- muže, kteří pochází z úspěšného chirurgického odběru spermií
Úspěšnost ICSI je podobná IVF - kolem 30-40 %. Většina klinik v ČR dnes používá ICSI jako standardní postup, i když není nutný, protože zvyšuje stabilitu oplodnění.
Co je to PICSI a IMSI? Pokročilé metody
PICSI a IMSI jsou pokročilé verze ICSI, které se zaměřují na výběr nejlepší spermie.
PICSI (physiologic ICSI) používá speciální petriovou misku s hyaluronanem - látkou, která přirozeně obklopuje vajíčko. Pouze ty spermie, které dokážou přilepit k hyaluronanu, jsou považovány za nejzralější a nejkvalitnější. To zvyšuje šanci na úspěšné oplodnění a snižuje riziko potratu.
IMSI (intracytoplasmic morphologically selected sperm injection) používá mikroskop s 6000násobným zvětšením, aby lékař viděl detaily spermie - tvar hlavičky, přítomnost vaků, strukturu chvostu. Pouze spermie bez významných vad jsou vybrány.
Obě metody nejsou standardně hrazeny, ale mohou být užitečné, pokud jste prošli několika neúspěšnými cykly IVF nebo máte opakované potraty. Náklady se pohybují kolem 15 000-25 000 Kč navíc na cyklus.
Co když nemáte vlastní vajíčka nebo spermie?
Někdy není možné použít vlastní gamety. V takovém případě existují dvě možnosti:
- Darovaná vajíčka - vajíčko od jiné ženy se oplodní spermií partnera nebo darovanou spermii. Embryo se přenese do dělohy příjemkyně. Úspěšnost je vysoká - až 50 %, protože vajíčka pocházejí od mladých, zdravých dárců.
- Darované spermie - používají se při mužské neplodnosti, nebo u jednotlivých žen a párů stejného pohlaví. Spermie pochází z banky, kde jsou pečlivě testovány na infekce a genetické choroby.
V ČR je darování vajíček a spermií anonymní. Dárce nemá právní nebo rodinné závazky k dítěti. Výběr dárce se dělá podle fyzických vlastností, krevní skupiny a genetického zdraví.
Co je kryokonservace a jak pomáhá?
Kryokonservace, neboli zamražování, je klíčová součást moderního umělého oplodnění. Po IVF nebo ICSI se nevyužitá embrya mohou zamrazit a uložit v kapalném dusíku. Můžete je použít později - bez nutnosti opakovat hormonální podporu.
Zamražená vajíčka jsou také možnost pro ženy, které:
- chcete odložit těhotenství kvůli kariéře nebo zdravotním důvodům
- se připravují na chemoterapii nebo záření
- mají vysoké riziko předčasného vyčerpání vajíček
Zamražená vajíčka zůstávají životaschopná i po 10 letech. Úspěšnost přenosu zamražených embryí je stejná jako u čerstvých - až 40 % u mladších žen.

Co se stane po přenosu embrya?
Po přenosu embrya je třeba čekat dvě týdny, než se provede test na těhotenství. Během této doby se doporučuje vyhýbat se stresu, těžké fyzické námaze a alkoholu. Některé ženy berou progesteronové přípravky, aby podpořily vývoj dělohy.
Pokud test je pozitivní, následuje první ultrazvukové vyšetření po 4-5 týdnech, kde se hledá srdcový tep. Pokud není těhotenství, lékaři analyzují, co mohlo selhat - a plánují další krok.
Co je důležité vědět před začátkem?
Umělé oplodnění není jen technický proces. Je to cesta, která vyžaduje fyzickou i emocionální odolnost.
- Cena: IUI stojí 5 000-10 000 Kč, IVF 30 000-45 000 Kč, ICSI s příslušenstvím 40 000-60 000 Kč. Veřejné pojištění hraje tři cykly do 39 let, ale jen pokud máte potvrzenou neplodnost.
- Čas: Celý cyklus trvá 4-6 týdnů. První pokus není vždy úspěšný - často je potřeba 2-4 cykly.
- Rizika: Vícevajíčková stimulace může vést k hyperstimulačnímu syndromu (tzv. OHSS), ale dnes je to velmi vzácné díky moderním protokolům. Riziko mnohoplodného těhotenství se snižuje tím, že se přenáší jen jedno nebo dvě embrya.
- Psychický tlak: Čekání na výsledek je náročné. Mnoho párů si vyhledává psychologickou podporu. To není známka slabosti - je to zdravá strategie.
Kde hledat pomoc v České republice?
V ČR je více než 40 klinik, které provádějí umělé oplodnění. Nejznámější jsou v Praze, Brně, Ostravě a Českých Budějovicích. Doporučuji vybírat kliniku podle:
- úspěšností (klinika musí zveřejňovat statistiky podle České společnosti pro reprodukční medicínu)
- zkušeností lékařů (nejméně 5 let praxe v této oblasti)
- možností konsultace s genetikem a psychologem
- průhledností cen a zahrnutých služeb
Nezapomeňte na první krok - vyšetření u gynekologa nebo reprodukčního specialisty. Bez přesné diagnózy není možné vybrat správnou metodu.
Co dělat, pokud se nic nepovede?
Někdy i po několika cyklech není těhotenství. To neznamená konec. Existují jiné cesty:
- Přijetí dítěte - adopce je možná i pro páry, které prošly umělým oplodněním.
- Surrogátka - v ČR je surrogátka nelegální, ale některé páry volí zahraniční řešení (např. Ukrajina, Georgia).
- Život bez dětí - to není selhání. Mnoho párů najde smysl v jiných formách rodiny - péči o příbuzné, dobrovolnictví, cestování, kariéře.
Největší chyba je čekat, až „všechno přijde samo“. Pokud už rok nebo více neuspějete, vyhledejte odborníka. Čím dříve začnete, tím větší máte šanci na úspěch - a tím méně emocionálního nákladu budete mít na zádech.
Je umělé oplodnění bolestivé?
Většina postupů je mírně nepříjemná, ale nebolestivá. Odběr vajíček se dělá pod lehkou anestézií - pacientka spí a nic necítí. Inseminace IUI je podobná běžné gynekologické prohlídce. Hormonální injekce mohou způsobit mírné bolesti v břiše nebo návaly horka, ale nejsou nevydržitelné.
Můžu si vybrat pohlaví dítěte při umělém oplodnění?
V České republice je výběr pohlaví dítěte zakázán, pokud není spojen s vážnou genetickou chorobou. Cílem je zabránit „designování“ dětí. Lékaři přenášejí embrya bez ohledu na pohlaví.
Kolik stojí jeden cyklus IVF v ČR?
Cena jednoho cyklu IVF se pohybuje mezi 30 000 a 45 000 korunami. Pokud máte plně hrazený cyklus z pojištění, zaplatíte jen 5 000-8 000 Kč za léky a doplňkové vyšetření. Více než 80 % klinik v ČR má s pojistkami uzavřené smlouvy.
Je možné použít vlastní spermie po operaci na varlaty?
Ano. Pokud nemáte spermie v ejakulátu, ale jsou v varlatech (např. po vředové infekci nebo vrozené vývojové vadě), lze je získat pomocí TESE (testikulárního odběru). Spermie se pak použijí v ICSI. Tento postup má úspěšnost podobnou běžnému ICSI.
Může být umělé oplodnění neúspěšné i při dobrých výsledcích vyšetření?
Ano. I když všechny vyšetření vypadají ideálně, oplodnění může selhat. Příčinou může být neviditelná genetická nekompatibilita, problémy s implantací embrya nebo neznámé faktory v buněčném prostředí. To není chyba pacienta - je to součást biologické složitosti.


Menu